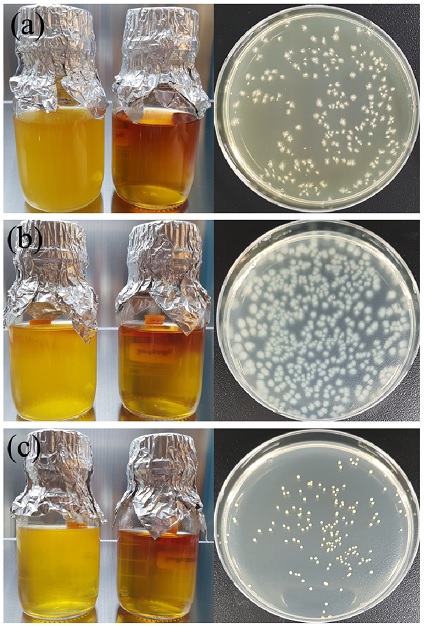
KSPE_2017_v34n12_933_f005.jpg
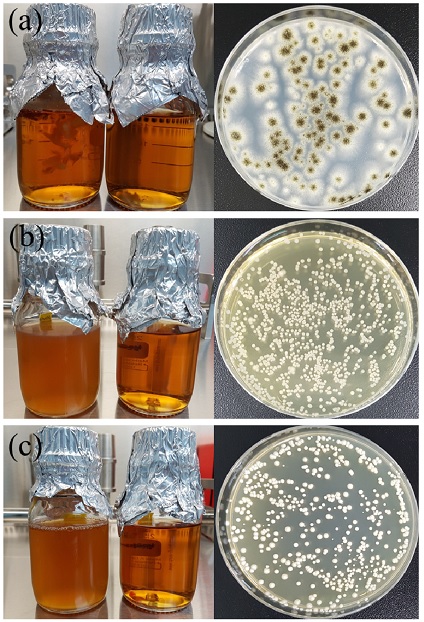
5

ABSTRACT
Recently, interbody fusion cage devices have been developed and used for lumbar reconstruction. Stand-alone cages reduce segmental mobility. In this study, we evaluated mechanical properties and biocompatibility of lumbar stand-alone cages. Evaluation of mechanical properties followed the ASTM F2077 standard that covers methods for static and fatigue testing. The sterility test was ensured by the ISO 11737-2. The extractable substances test was ensured by the Korea pharmacopoeia. Cytotoxicity of the specimen was assessed using MTT assay as recommended by the international standard guidelines, ISO 10993-Part 5 for in vitro testing.
-
KEYWORDS: Stand-alone cage, Static compressive test, Dynamic compressive test, Tests of sterility, Extractable substances test, Cytotoxicity test
-
KEYWORDS: 자립형 추간체 유합 보형재, 정적압축시험, 동적압축시험, 무균시험, 용출물시험, 세포독성시험
1. 서론
척추체는 몸통을 이루는 32-35개의 척추골(Vertebra)과 척추골 사이의 추간원판(Intervertebral Disk) 즉, 디스크로 이루어지며, 체간의 지주를 이루면서 상단의 두개골과 하단의 골반을 연결하는 우리 몸의 중추를 이루는 부분이다.
퇴행성 척추 질환(Degenerative Spinal Diseases)중 대표적으로 추간판(Intervertebral Disc) 퇴행이 있으며, 이는 추간판 물질의 수화(Hydration) 손실에 의한 것이다. 추간판 내의 수액 손실은 디스크의 높이 감소와 생체 역학적 변화를 야기시켜, 척추 주변의 근육과 인대 같은 다른 구조물들의 활동에 부정적인 영향 및 고통을 유발시킬 수 있다. 또한 퇴행화에 따른 추간판 높이의 감소는 후관절의 응력을 증가시키며, 결국 이런 변화는 신경근(Nerve Roots)을 압박하는 원인이 되기도 한다.
이러한 경우 보편적으로 손상된 디스크를 제거하고 인접한 척추 골 사이에 추간체 유합 보형재(Interbody Fusion Device, Cage) 및 전방 척추용 금속판(Anterior Spinal Plate) 등 고정기기를 이용하여 불안정한 척추 분절을 고정하는 추간판 제거술 및 유합술(Anterior Spinal Discectomy and Fusion)이 시행된다.
1,2
하지만 시술 후 추간체 유합 보형재의 침강, 이탈 등의 문제점들이 보고되고 있으며,
3 또한 분절의 운동성 제한 및 비정상적인 하중 분담으로 인한 추가적인 퇴행을 야기시기는 것으로 보고되고 있다.
4 이러한 문제점 보완을 위해 나사를 통한 고정력 향상 및 시술 후 침강 및 이탈 현상을 방지함으로써 골 유합률을 향상시킬 수 있는 자립형 추간체 유합 보형재(Stand-Alone Cage)가 개발되고 있다.
본 연구에서는 자립형 추간체 유합 보형재의 역학적 평가(정적압축시험, 동적압축시험), 무균시험, 용출물시험, 세포독성시험을 수행하여 성능 및 생물학적 안전성을 확인하였다.
2. 시험 방법
2.1 시험 시료
본 실험에 사용된 요추용 추간체 유합 보형재(ALIF Stand-Alone Cage-2846-4818, GS Medical, Osong, Korea)는 가로 30 mm, 세로 24 mm, 높이 18 mm로, 요추부의 척추체 형상 및 해부학적 구조를 고려하여 볼록한 형상(Convex Shape)을 구현하여 설계하였으며 스크류(Screw)의 이탈 방지를 위한 잠김 금속 플레이트(Locking Plate)를 설계되었다(
Fig. 1). 비교적 많은 하중을 지지하는 요추부에 사용되는 제품이므로 생체적합성뿐 아니라 구조적 안전성을 고려하여 추간체 유합 보형재의 바디(Body) 부분은 최근 우수한 기계적 강도로 금속 소재를 대신할 의료용 폴리머 소재로 각광받는 PEEK (Polyether Ether Ketone)로, 전방 플레이트(Plate) 및 스크류 부분은 대표적 의료용 금속소재인 티타늄합금(Ti6Al4V)으로 제작되었다. 모든 시료는 감마 멸균 후 평가를 진행하였다.
Fig. 1The lumbar stand-alone cage

2.2 역학적 평가
2.2.1 정적 압축시험
자립형 추간체 유합 보형재의 동적압축시험의 시험하중을 결정하기 위해 ASTM F2077(Test Methods for Intervertebral Body Fusion Devices) 규격의 절차에 따라 정적압축시험(Static Compressive Test)을 진행하였다.
5 ASTM F2077에서 권장한 방법에 따라, 추간체 유합 보형재의 추간판 내 높이를 15 mm로 설계한 한 쌍의 스테인리스스틸(Stainless Steel) 지그를 제작하였다.
Fig. 2(a)와 같이 만능재료시험기 (MTS 858, MTS System Corp., MN, USA)에 장착하고 변위속도를 25 mm/min으로 제품이 파손될 때까지 압축한다. 이로부터 얻은 하중-변위곡선에서 2% Offset 항복 하중 및 변위를 확인하였다.
Fig. 2Assembly of stand-alone cage for (a) static compressive test, (b) dynamic fatigue test

2.2.2 동적 압축시험
동적압축시험(Dynamic Compressive Test)은 ASTM F2077에서 권장한 방법에 따라, 정적 압축시험에서 사용된 지그와 동일하게 설계된 한 쌍의 Polyacetal 지그를 제작하였다.
Fig. 2(b)와 같이 만능재료시험기에 시험 지그 및 시료를 장착하고, 압축 항복하중의 25% 하중에서 5 Hz의 피로주기, 5 × 10
6의 반복수의 조건으로 6개의 시료를 시험하였다.
2.3 무균 시험
2.3.1 무균시험 사용 균주 및 배지
혐기성 균주 1종(Clostridium Sporogenes), 진균 2종(Candida Albicans, Aspergillus Brasiliensis), 호기성 균주 3종(Staphylococcus Aureus, Bacillus Subtilis, Pseudomonas Aeruginosa)을 사용하였다. 혐기성 균주는 배지 Fluid Tioglycollate Medium (FTM)에, 진균 및 호기성 배지는 Tryptic Soy Broth (TSB)에 배양하였다.
2.3.2 무균시험 시험방법
무균시험은 ISO 11737-2에 의거하여 시험하였다.
6 본시험 전에 조제한 배지의 성능을 시험하기 위해 배지성능시험을 실시하였다. FTM에는 Clostridium Sporogenes, Pseudomonas Aeruginosa, Staphylococcus Aureus를 접종하여 (32.5 ± 2.5)°C 조건으로 배양하였으며, TSB에는 Aspergillus Brasiliensis, Bacillus Subtilis, Candida Albicans를 접종하여 (22.5 ± 2.5)°C 조건으로 배양하였다. 호기성균과 혐기성균의 경우 3일, 진균의 경우 5일을 넘지 않도록 배양하였다.
본시험은 직접법으로 실시하였으며, 시료량이 배지용량의 10%를 넘지 않도록 FTM와 TSB에 각각 접종하였다. 접종후 FTM는 (32.5 ± 2.5)°C 조건으로, TSB는 (22.5 ± 2.5)°C 조건으로 14일 이상 배양하였다.
2.4 용출물시험
용출물시험은 대한약전 플라스틱제 의약품용기시험법 용출시험 및 중금속 시험법에 의거하여 시험되었다. 시험물질의 조제를 위해서 추출용매를 증류수로 하여 시료 4.0 g에 50 ± 2.0°C, 72시간 용출하여 검액을 만들고 동일한 방법으로 공시험액을 만들어 시험하였다.
2.4.1 성상시험
성상시험은 용출물로부터 나오는 물질을 확인하기에 가장 간단한 확인방법으로 육안관찰로 제품의 표면에 붙어 있는 입자나 색소의 용출로인한 용출용매의 색변화를 관찰하는 방법으로 진행되었다. 검액 5 mL을 시험관에 넣고 흰색을 배경으로 하여 관찰하였다.
2.4.2 pH 시험
pH 시험은 인체 내의 pH는 일정하게 유지가 되나 의료기기로 인해 체내 pH 변화를 일으킬 수 있으며 이를 측정하기 위하여 진행되었다. 검액 및 공시험액 20 mL 씩을 취하여 여기에 염화칼륨 1.0 g을 물에 녹여서 1000 mL로 한 용액 1.0 mL씩을 넣고 두액의 pH을 측정하여 그 차이를 산출하였다.
2.4.3 중금속시험
중금속시험은 인체에 장기간 걸쳐 유해한 작용을 하는 중금속 (미지의 2가 중금속이온)이 용출되는지 확인하기 위하여 진행되었다. 검액 및 공시험액을 10 mL 취하여 네슬러관에 취하고 공시험액에 납표준액을 2 mL 넣는다. 여기에 황화나트륨 3방울과 묽은 초산 2 mL을 넣은 후 백색바탕에서 비교액과 비교하였다.
2.4.4 과망간산칼륨환원성물질시험
과망간산칼륨환원성물질시험은 강력한 산화제인 과망간산칼륨을 사용하여 용출용매에 유기물이나 무기물의 존재유무를 확인하기 위하여 진행되었다. 검액 10 mL를 마개 달린 삼각플라스크에 취하고, 묽은황산 1 mL를 넣고 0.002 mol/L 과망간산 칼륨액 20.0 mL 넣은 다음 3분간 끓여 식힌 다음 요오드화칼륨 0.10 g을 넣어 마개를 단단히 하고 흔들어 섞어 10분간 방치한 다음 0.01 mol/L 티오황산나트륨액으로 적정한다(지시약 전분시약 5방울). 따로 공시험액 10.0 mL를 써서 같은 방법으로 조작한다. 검액 및 공시험액의 0.002 mol/L 과망간산칼륨액의 소비량의 차이를 산출하였다.
2.4.5 증발잔류물시험
증발잔류물시험은 용출용매에 미지의 물질이 용출되었는지 여부를 확인하기 위하여 진행되었다. 검액 10 mL를 취하여 수욕상에서 증발건조하고 잔류물을 105°C에서 1시간 건조하여 무게를 달고, 증발전의 무게와 증발 후의 무게 차를 산출하였다.
2.4.6 자외선흡수스펙트럼시험
자외선흡수스펙트럼시험은 눈에 보이지 않는 자외부 영역대에서 미지의 물질을 확인하기 위하여 진행되었다. 검액을 가지고 공시험액을 대조로 하여 흡광도 측정법에 따라 시험하여 파장 250-350 nm의 각각의 구간에서의 최대 흡광도를 기록하였다.
2.5 세포독성시험
세포독성시험은 ISO 10993-5에 의거하여 시험되었다.
7 시험방법은 현미경 관찰을 이용한 정성적인 방법과 MTT (3-(4,5-Dimethylthiazol-2-yl)-2,5-Diphenyltetrazoliumbromid) Test를 이용한 정량적인 방법으로 진행되었다. 현미경 관찰은 세포의 단층 배양과 그 형태 및 세포의 양을 현미경으로 확인하고, 6 Well Plate에 각 Well 당 1 × 10
5 Cells/mL 농도의 세포를 2 mL씩 각 Well에 분주하였다. 1일 배양 후 세포의 단층배양상태를 확인하고, 세포의 Confluency가 80% 이상이면, 각 Well의 배양액을 제거한 후 대조군, 음성대조물질, 양성대조물질, 시험물질의 용출액을 각 Well 당 2 mL씩 처리하였고 반응시간은 초기, 24시간, 48시간으로 배양하였다. MTT Test는 세포의 양을 MTT Assay를 이용하여 570 nm에서 흡광도를 확인하고, 96 Well Plate에 1 × 10
5 Cells/mL농도의 세포를 각 Well에 분주하였다. 1일 배양 후 세포의 단층배양상태를 확인하고, 세포의 Confluency가 80% 이상이면, 각 Well의 배양액을 제거한 후 대조군, 음성대조물질, 양성대조물질, 시험물질의 용출액을 각 Well 당 0.1 mL씩 처리하였고 반응시간은 24시간 동안 37°C 에서 5% CO
2 배양기에서 배양하였다.
3. 결과 및 고찰
본 연구에서 수행한 정적압축시험의 하중-변위 그래프(Load-Displacement Curve)를 나타냈으며, 탄성 구간을 기준으로2% offset하여 항복하중을 확인하였다(
Fig. 3). 그 결과 평균 항복 하중 80.44 kN, 평균 항복 변위 2.19 mm의 결과값을 나타내었다. 시험 완료 후 시료를 육안으로 관찰해본 결과, PEEK 바디 부분에서 압축운동에 따른 변형이 나타났다. 하지만, 본 시험 조건에서는 Ti6Al4V으로 제작된 전방 플레이트 부분에서의 파손은 거의 관찰할 수 없었다.
Fig. 3 Load-Displacement curve of specimen

정적압축시험 항복하중 결과의 25% 하중으로 진행한 동적압축시험 결과, 시험을 진행한 모든 시료가 5 × 10
6 Cycle의 반복주기를 견뎠으며, 시험 완료된 시편의 파단 및 변형은 확인할 수 없었다. 더욱 정확한 확인을 위하여, PEEK로 이루어진 바디 부분의 미세적인 변화를 확인하기 위하여 시료 이탈방지를 위한 톱니의 측면을 실체현미경(SZ61, Olympus, Tokyo, Japan)으로 확대 관찰하였다. 다수의 연구에서 하중을 받는 인공관절의 마모에 의한 생성된 마모입자가 골용해를 유발하여 식립품 이탈의 원인이 된다고 발표 하였다.
8 본 실험 결과에서는 시료의 변형 및 마모는 나타나지 않았다(
Fig. 4). 일반적으로 보형재의 유합은 이식 후 1년 내에 잘 이루어진다. 그러므로 보형재는 유합이 일어날 때까지 정상적인 추간판 내 척추 부하에 견딜 수 있어야 한다. Hedman, T. P. 등은 본 시험의 반복횟수 기준인 5 × 10
6 Cycle은 실제 추간판 내 척추 부하에서 2.5년에 상응한다고 하였다.
9 그러므로 본 시험의 보형재는 역학적으로 안전하다고 판단된다.
Fig. 4 Side view image of stand-alone cage (a) before fatigue test, (b) after fatigue test

일반적으로 추간체 유합 보형재는 추간체 협착증 및 척추 분리증 등의 척추 질병을 치료하기 위해 디스크를 제거하거나 척추 뼈의 일부를 절제한 이후 보형재를 삽입하고 고정용 플레이트 및 스크류로 척추체를 고정시키는 방법으로 사용되기 때문에 여러 부위의 절개가 추가될 수 있다. 본 연구에서 사용된 자립형 추간체 유합 보형재는 보형재, 고정용 플레이트, 스크류가 일체화 되어있어 한번의 절개로 가능한 장점이 있다.
10,11 하지만 아직까지 자립형 추간체 유합 보형재를 평가하기 위한 국제 규격이 발표되지 않았기 때문에 본 연구에서는 일반 추간체 유합 보형재의 평가 규격인 ASTM F2077을 적용하여 스크류의 식립 특성은 고려하지 않고 보형재 바디만의 독립적인 물성만을 평가하였다. 점차 자립형 추간체 유합 보형재에 대한 관심이 높아지는 만큼 적절한 규격의 개발이 시급하다고 사료된다.
배지성능시험 결과 모든 균주가 FTM과 TSB에 적합하게 자라 배지의 색이 뿌옇게 변하였으며,선택배지에 접종하여 배양되는 것을 확인하였다(
Figs. 5 and
6). 이 결과 배지가 적합하다고 판단하고 본 시험을 진행하였으며, 본 시험의 경우 14일 배양 후 FTM과 TSB배지 모두 뿌옇게 변하지 않아 음성으로 판정하였다(
Fig 7). 추가적으로 정량적 확인을 위해 고체배지(Fluid Tioglycollate Agar, Tryptic Soy Agar)에 시료를 접종하였으며, Colony가 자라지 않아 최종적으로 음성으로 판정하였다(
Figs. 8 and
9).
Fig. 5 Suitability test of media (Fluid Tioglycollate Medium) (a) Clostridium sporogenes, (b) Pseudomonas aeruginosa, (c) Staphylococcus aureus

Fig. 6 Suitability test of media (Tryptic Soy Broth) (a) Aspergillus brasiliensis, (b) Bacillus subtilis, (c) Candida albicans

Fig. 7 Test result (a) Fluid tioglycollate medium(14 day), (b) Tryptic soy broth(14 day)

Fig. 8 Final test (Fluid Tioglycollate Agar) (a) Tryptic soy broth (Negative Control), (b) Tryptic soy broth (Sample), (c) Fluid tioglycollate medium (Negative Control), (d) Fluid tioglycollate medium (Sample)

Fig. 9 Final test (Tryptic Soy Agar) (a) Tryptic soy broth (Negative Control), (b) Tryptic soy broth (Sample), (c) Fluid tioglycollate medium (Negative Control), (d) Fluid tioglycollate medium (Sample)

용출물로부터 나오는 가소제, 윤활제, 안정제, 색소 등을 확인하기 위한 성상시험 결과 용출용매의 색변화를 관찰하였으나 무색투명으로 색변화가 나타나지 않았다. 수소이온의 농도차이를 확인하여 전위를 가지는 물질의 존재유무를 확인하는 pH 시험결과 공시험액과 검액의 pH차가 시험기준 (pH = 1.5)보다 작은 pH = 0.42로 확인되었다. 중금속이 용출되는지 확인하기 위한 중금속 시험 결과 색변화를 관찰하였으나 색변화가 나타나지 않았다. 유기물이나 무기물의 존재유무를 확인하기 위해서 과망간산칼륨액의 소비량의 차이를 확인하는 과망간산칼륨환원성물질시험 결과 공시험액과 검액의 과망간산칼륨액의 소비량의 차이가 시험기준(2 mL)보다 작은 0.9 mL로 확인되었다. 미지의 물질이 용출되었는지 여부를 확인하는 정량적 증발잔류물시험 결과 공시험액과 검액의 잔류물 차이가 시험기준 (1.0 mg)보다 작은 0.1 mg으로 확인되었다. 자외선영역대에서 미지의 물질을 확인하고자 하는 자외선흡수스펙트럼시험 결과 공시험액과 검액의 흡광도 차이가 시험기준 (0.1 AU)보다 작은 0.0 AU로 확인되었다. 모든 시험결과가 시험기준치를 넘지 않았으므로, 본 시험 조건하에서 사용된 시험물질은 용출물시험에 합격한 것으로 사료된다.
세포독성시험은 배양 후 초기, 24시간, 48시간에 현미경을 이용하여 세포의 성장 정도 및 용해 정도를 관찰하였다. 관찰 결과는
Table 1에 따라 등급을 판정하였다.
7 음성대조군이 0등급, 양성대조군이 4등급 이상일 경우, 시험상태가 적합한 것으로 판단하였다. 시험물질을 관찰한 결과, 판정 등급이 2이하일 경우, 시험물질에 세포독성이 없는 것으로 판정하였다. 그 결과,
Table 2와 같이 음성대조물질 용출액을 적용한 세포는 0등급, 양성대조 물질 용출액을 적용한 세포는 4등급으로서, 시험과정 및 시험조건 중 특이사항은 없었다. 시험물질 용출액의 결과는 0등급으로 세포의 용해 정도나 성장저해 정도가 거의 나타나지 않았으므로, 본 시험 조건하에서 사용된 시험물질은 세포독성이 없는 것으로 사료된다.
Table 1 Qualitative morphological grading of cytotoxicity of extracts
Table 1
|
Grade |
Reactivity |
Conditions of all cultures |
|
0 |
None |
Discrete intracytoplasmatic granules, no cell lysis, no reduction of cell growth |
|
1 |
Slight |
Not more than 20% of the cells are round, loosely attached and without intracytoplasmatic granules, or show changes in morphology; occasional lysed cells are present; only slight growth inhibition observable |
|
2 |
Mild |
Not more than 50% of the cells are round , devoid of intracytoplasmatic granules, no extensive cell lysis; not more than 50% growth inhibition observable |
|
3 |
Moderate |
Not more than 70% of the cell layers contain rounded cells or are lysed; cell layers not completely destroyed, but more than 50% growth inhibition observable |
|
4 |
Severe |
Nearly complete or complete destruction of the cell layers |
Table 2 Result of qualitative morphological grade
Table 2
|
Grade |
|
Initial |
24 hour |
48 hour |
|
Test sample |
0 |
0 |
0 |
0 |
0 |
0 |
0 |
0 |
0 |
|
Negative control |
0 |
0 |
0 |
0 |
0 |
0 |
0 |
0 |
0 |
|
Positive control |
0 |
0 |
0 |
4 |
4 |
4 |
4 |
4 |
4 |
|
Control |
0 |
0 |
0 |
0 |
0 |
0 |
0 |
0 |
0 |
MTT Test는 배양 24시간 후 MTT Assay를 이용하여 세포의 성장 정도를 570 nm에서 흡광도를 측정하여 확인하였다. 살아있는 세포의 수가 감소하면 대사활동이 감소하여 MTT와 반응하지 못해 청보라색의 Formazan의 양이 적어 흡광도 값이 공시험액의 양보다 낮게 측정된다. 이는 Cell Viability %(Viab. %) 값이 낮을수록 시험물질의 세포독성이 있음을 의미하며, 생존율이 대조군의 70% 미만으로 감소되는 경우 세포독성이 있다고 판단된다. (Viab. % 값은 아래의 방정식을 이용하여 판단)
*OD570e : 시험 검체의 100% 용출물에 대해 측정된 광도의 평균값
*OD570b : 공시험액에 대해 측정된 광도의 평균값
그 결과,
Table 3과 같이 음성대조물질 용출액을 적용한 세포는 생존율이 대조군의 70% 이상, 양성대조물질 용출액을 적용한 세포는 생존율이 대조군의 70%미만으로서, 시험과정 및 조건 중 특이사항은 없었다. 시험물질 용출액의 결과는 생존율이 70%이상으로서, 세포성장저해 정도가 거의 나타나지 않았으므로, 본 시험 조건하에서 사용된 시험물질은 세포독성이 없는 것으로 사료된다.
Table 3 Cell viability of MTT test
Table 3
|
Cell viability (%) |
|
Negative control |
100 |
|
Positive control |
8.3 |
|
Test sample |
95.9 |
4. 결론
본 연구에서는 자립형 추간체 유합 보형재의 의료기기 허가과정에서 필수적으로 수행하는 시험인 성능 및 안전성 평가를 수행하였다. 시험항목은 미국재료시험규격, 국제표준화기구규격, 생물학적 안전에 관한 공통기준규격, 대한민국 약전에 의거하여 선택 후 평가를 진행하였다.
역학적 평가 결과 최대 항복하중은 80.44 kN으로 측정되었으며, 최대 항복하중의 25%의 하중으로 수행한 피로시험에서는 파손 및 변형은 나타나지 않았다. 용출물시험결과 시험기준을 모두 충족하였으며, 직접법으로 수행한 무균시험은 무균성을 확인하였으며, 시료의 멸균 유무를 확인할 수 있었다. 현미경관찰법과 MTT Test로 확인한 세포독성시험 결과 모두 세포독성은 없는 것으로 확인되었다. 본 시험기준에 적합하다고 판정되었을 경우 의료기기 허가 시 평가결과가 사용 가능하고, 시간단축, 비용절감 등 효과가 기대된다.
또한 침강, 이탈, 분절의 운동성 제한 및 비정상적인 하중 분담으로 인한 추가적인 퇴행 등 여러 가지 문제점들이 보완 가능한 추간체 유합 보형재에 대한 의료기기 개발로 추간판 내의 수액 손실로 인한 척추 디스크에 부정적인 영향을 줄여 퇴행성 척추 질환을 감소시키는데 기여할 수 있을 것으로 기대된다.
본 연구개발을 통하여 국내 기술 개발을 통한 수입대체효과 및 대외 수출을 통한 국가 이미지 제고, 신기술 개발을 통한 기술경쟁력 구축 및 확보, 산·연간 연계를 통한 연구 기반 구축, 시술 시간 단축을 통한 시술 효과 극대화 및 양질의 의료서비스 제공 등 기대성과를 이룰 수 있다.
ACKNOWLEDGMENTS
이 논문은 2013년도 보건복지부의 재원으로 첨단의료산업진흥재단의 지원을 받아 수행한 첨단의료복합단지 연구개발지원사업임(HO13C0004).
REFERENCES
- 1.
McAfee, P. C., DeVine, J. G., Chaput, C. D., Prybis, B. G., Fedder, I. L., et al., “The Indications for Interbody Fusion Cages in the Treatment of Spondylolisthesis: Analysis of 120 Cases,” Spine, Vol. 30, No. 6S, pp. S60-S65, 2005.
10.1097/01.brs.0000155578.62680.dd
- 2.
Gerber, M., Crawford, N. R., Chamberlain, R. H., Fifield, M. S., LeHuec, J.-C., et al., “Biomechanical Assessment of Anterior Lumbar Interbody Fusion with an Anterior Lumbosacral Fixation Screw-Plate: Comparison to Stand-Alone Anterior Lumbar Interbody Fusion and Anterior Lumbar Interbody Fusion with Pedicle Screws in an Unstable Human Cadaver Model,” Spine, Vol. 31, No. 7, pp. 762-768, 2006.
10.1097/01.brs.0000206360.83728.d2
- 3.
Abbushi, A., Čabraja, M., Thomale, U.-W., Woiciechowsky, C., and Kroppenstedt, S. N., “The Influence of Cage Positioning and Cage Type on Cage Migration and Fusion Rates in Patients with Monosegmental Posterior Lumbar Interbody Fusion and Posterior Fixation,” European Spine Journal, Vol. 18, No. 11, pp. 1621-1628, 2009.
10.1007/s00586-009-1036-3
- 4.
Cain, C. M., Schleicher, P., Gerlach, R., Pflugmacher, R., Scholz, M., et al., “A New Stand-Alone Anterior Lumbar Interbody Fusion Device: Biomechanical Comparison with Established Fixation Techniques,” Spine, Vol. 30, No. 23, pp. 2631-2636, 2005.
10.1097/01.brs.0000187897.25889.54
- 5.
ASTM F2077-11, “Test Methods for Intervertebral Body Fusion Devices,” 2011.
- 6.
ISO 11737-2, “Sterilization of Medical Devices - Microbiological Methods - Part 2: Tests of Sterility Performed in the Definition, Validation and Maintenance of a Sterilization Process,” 2009.
- 7.
ISO 10993-5, “Biological Evaluation of Medical Devices - Part 5: Tests for in Vitro Cytotoxicity,” 2009.
- 8.
ISO 10993-12, “Biological Evaluation of Medical Devices - Part 12: Sample Preparation and Reference Materials,” 2012.
- 9.
Ren, K., Dusad, A., Zhang, Y., and Wang, D., “Therapeutic Intervention for Wear Debris-Induced Aseptic Implant Loosening,” Acta Pharmaceutica Sinica B, Vol. 3, No. 2, pp. 76-85, 2013.
10.1016/j.apsb.2013.02.005
- 10.
Hedman, T. P., Kostuik, J. P., Fernie, G. R., and Heller, W. G., “Design of an Intervertebral Disc Prosthesis,” Spine, Vol. 16, No. 6S, pp. S256-S260, 1991.
10.1097/00007632-199106001-00016
- 11.
Kornblum, M. B., Turner, A. W., Cornwall, G. B., Zatushevsky, M. A., and Phillips, F. M., “Biomechanical Evaluation of Stand-Alone Lumbar Polyether-Ether-Ketone Interbody Cage with Integrated Screws,” The Spine Journal, Vol. 13, No. 1, pp. 77-84, 2013.
10.1016/j.spinee.2012.11.013